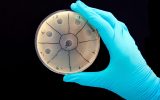

25 марта
-
20:04
Исследование: потоки после осадков переносят микропластик в глубины океанов
 Наука
Наука
-
19:29
Новая математическая модель предсказывает мутации вирусов
 Новости
Новости
23 марта
-
21:58
Новый гироскоп оказался в 10 тыс. раз точнее аналогов
 Новости
Новости
-
20:59
Новый аппарат в четыре раза ускорит пересадку органов
 Наука
Наука
22 марта
-
20:11
Ученые отследили суперземлю рядом с ближайшей к Солнцу звездой
 Наука
Наука
-
19:13
Иглы, вдохновленные паразитами, сделают уколы безболезненными
 Новости
Новости
-
17:18
Исследование: исчезнувший континент был больше, чем считалось ранее
 Наука
Наука
-
16:08
Появился быстрый способ очистки воды
 Наука
Наука
-
13:26
Ровер Curiosity прислал селфи с Марса
 Новости
Новости
-
12:39
Ученые хотят заменить антибиотики программируемыми вирусами
Наука
Наука
21 марта
-
19:38
Устали паниковать из-за коронавируса? Раскраска в VR поможет вам расслабиться
 COVID-19
COVID-19
-
18:36
Ученые приблизились к созданию «вечного стекла»
 Наука
Наука
-
17:10
Twitter будет ускоренно верифицировать экспертов в области здравоохранения
 COVID-19
COVID-19
-
15:22
Таяние ледников Гренландии подняло уровень мирового океана на 2,2 миллиметра за два месяца
 Наука
Наука
-
14:33
Google открыл сайт с информацией о коронавирусе и улучшил поисковую выдачу
 COVID-19
COVID-19
-
12:10
Иннополис снял сериал про искусственный интеллект
 Город
Город
20 марта
-
21:10
Алгоритм на основе спутниковых данных помогает избежать засуху
 Наука
Наука
-
19:49
Комета ATLAS становится рекордно яркой
 Наука
Наука

